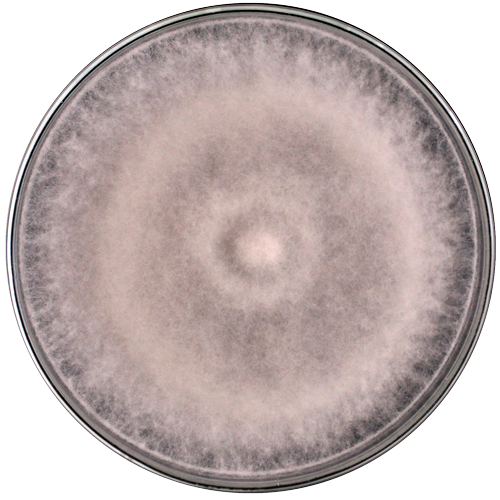

$97.298 más I.V.A.
RGM 2259
Categoría:
Género:
Botrytis
Especie:
prunorum
Cepa tipo:
Si
Código de otra colección:
BPRU-21
Fecha de aislamiento:
2012
País de origen:
Chile
Historial de deposito:
Instituto de Investigaciones Agropecuarias (INIA) <- Pontificia Universidad Católica de Chile
Sustrato de origen:
Vegetal (Flores de Ciruelo Japoneses (Prunus salicina))
Acceso GenBank:
KP234036; KP339980; KP339994; KP339987; KR732658
Temperatura óptima de crecimiento:
20º
Regiónalizas secuenciada:
ITS/RPB2/G3PDH/HSP60/LSU
Medio de cultivo:
Agar papa dextrosa
Nivel de riesgo:
Restricciones de distribución:
Sin restricción de distribución
Información adicional:
https://apsjournals.apsnet.org/doi/10.1094/PHYTO-06-15-0143-R
Fecha de subida al catálogo:
2024-06-04
Secuencias nucleotídicas:
2024-06-04
Otros comentarios: